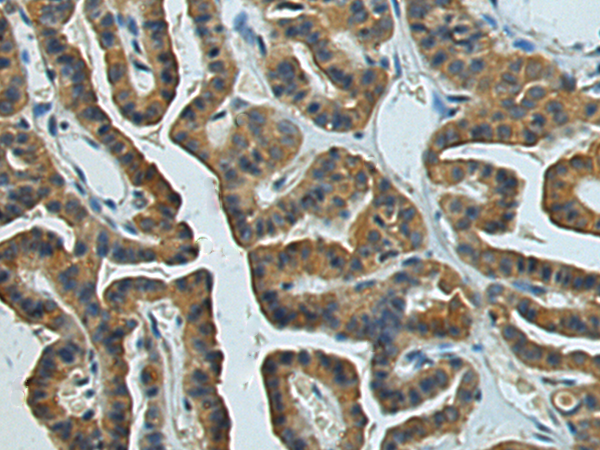

|
Background: |
This gene was identified by its induced expression in B lymphocytes in response Epstein-Barr virus infection. It encodes a secreted glycoprotein belonging to the hematopoietin receptor family, and heterodimerizes with a 28 kDa protein to form interleukin 27 (IL-27). IL-27 regulates T cell and inflammatory responses, in part by activating the Jak/STAT pathway of CD4+ T cells. |
|
Applications: |
ELISA, WB, IHC |
|
Name of antibody: |
EBI3 |
|
Immunogen: |
Fusion protein of human EBI3 |
|
Full name: |
Epstein-Barr virus induced 3 |
|
Synonyms: |
IL27B; IL35B; IL-27B |
|
SwissProt: |
Q14213 |
|
ELISA Recommended dilution: |
5000-10000 |
|
IHC positive control: |
Human thyroid cancer |
|
IHC Recommend dilution: |
150-300 |
|
WB Predicted band size: |
25 kDa |
|
WB Positive control: |
Mouse kidney tissue, 293T cell lysates |
|
WB Recommended dilution: |
500-2000 |

購(gòu)物車(chē)
購(gòu)物車(chē) 幫助
幫助
 021-54845833/15800441009
021-54845833/15800441009
